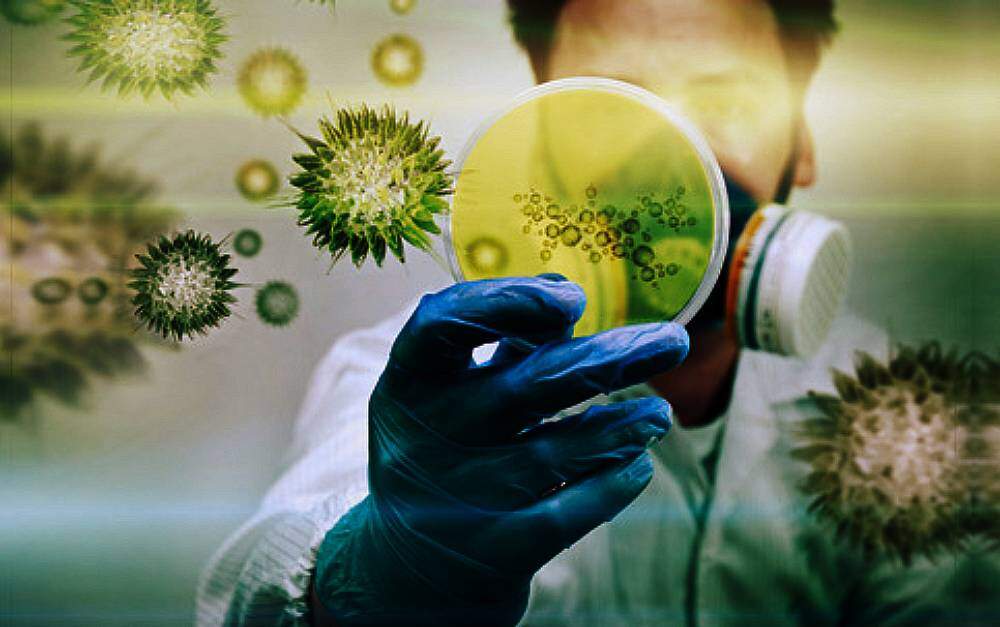

Sábado, 13 de junho de 2026
Sábado, 13 de junho de 2026
Por Redação do Jornal O Sul | 6 de dezembro de 2021

A detecção de bactérias resistentes a antibióticos triplicou no Brasil durante a pandemia de covid-19. Os dados são do Laboratório de Pesquisa em Infecção Hospitalar do Instituto Oswaldo Cruz (IOC/Fiocruz). O órgão é referência nacional na vigilância das chamadas superbactérias. Além do crescimento no número de amostras desses microoganismos, houve aumento da sua resistência a remédios. Isso é ainda mais preocupante. Quer dizer que, cada vez mais, os medicamentos disponíveis contra as bactérias não funcionam.
O processo tem sido acelerado pelo consumo excessivo – e muitas vezes incorreto – de remédios na pandemia. O aumento dessa resistência, porém, não é um problema apenas brasileiro. É uma ameaça global. A capacidade de tratar infecções é considerada uma das maiores conquistas da medicina moderna. Agora, está sob ameaça.
Em 2019, o laboratório da Fiocruz recebeu cerca de mil amostras de superbactérias de diversos estados para análise aprofundada. Em 2020, primeiro ano da pandemia, o número passou para 2 mil. Já em 2021, apenas de janeiro a outubro, já são mais de 3,7 mil amostras confirmadas. É um aumento de mais de três vezes sobre o pré-pandemia. As infecções causadas por superbactérias geralmente são associadas à alta mortalidade.
“Durante a emergência sanitária provocada pela Covi-19, houve um aumento significativo no número de pacientes internados em estado grave e por longos períodos, que apresentam maior risco de infecção hospitalar”, afirmou a chefe do laboratório, Ana Paula Assef. “Também houve aumento no uso de antibióticos, o que eleva a pressão seletiva sobre as bactérias. É um cenário que favorece a disseminação da resistência, agravando ainda mais um problema de alto impacto na saúde pública.”
O infectologista Ésper Kallas, do Hospital Vila Nova Star, da Rede D’Or, é mais otimista. Segundo ele, o aumento é um reflexo direto do crescimento do número de pacientes internados por causa da covid-19. Deve cair tão logo a pandemia termine, avalia.
“Os sistemas de saúde ficaram sobrecarregados por conta do número de pacientes graves; muitas UTIs tiveram que se multiplicar para acomodar pacientes, algumas vezes sem estrutura”, afirma o especialista. “Toda vez que isso acontece, há um aumento de infecção hospitalar, não é surpreendente. Agora que o número de casos caiu, muito provavelmente vamos ver uma redução.”
Mutações aleatórias
As bactérias se multiplicam a cada 20 minutos. Às vezes, sofrem mutações aleatórias. Elas funcionam como escudo contra algum antibiótico. Quando ele é ministrado a um paciente, mata a população de bactérias no organismo. Mas aquelas que sofreram a mutação não morrem, se multiplicam. Criam assim uma nova linhagem e não são afetadas pelo remédio.
Esse é o mecanismo básico de desenvolvimento de uma superbactéria. Algumas são resistentes a determinadas classes de antibióticos. Mas outras são imunes a todos. Drogas da década de 50, que haviam sido abandonadas por causa de efeitos colaterais, voltaram ao arsenal médico para enfrentar as variantes resistentes.
A perspectiva de surgimento de novos medicamentos contra bactérias é muito baixa. Segundo a Organização Mundial de Saúde (OMS), só existem 43 antibióticos em ensaios clínicos atualmente no mundo. Ao mesmo tempo, são mais de 5,7 mil tratamentos contra o câncer. A pesquisa e desenvolvimento de uma nova droga constituem processo longo e caro. Lançar no mercado um antibiótico que logo cairá em desuso, por causa do avanço das superbactérias, não é economicamente vantajoso para as empresas.
Desafio internacional
O problema é mundial. Segundo a OMS, 700 mil pessoas morrem por ano de infecções por superbactéria. Um estudo do Banco Mundial, de 2015, que se tornou referência, indica que, até 2050, o número anual dessas mortes chegará a dez milhões. Assim, ultrapassará até as mortes por câncer.
Em fevereiro, a OMS lançou um alerta. Pediu que “a crise da covid-19 não se transforme em uma catástrofe de resistência aos antimicrobianos”. Mais recentemente, a organização criou um painel de cientistas. Quer assim identificar quais antibióticos são essenciais para a saúde humana. O objetivo é “blindar” o seu uso, para que sigam funcionando. Esses remédios são a tropa de elite dos medicamentos.
“Bactérias como Acinetobacter e Pseudomonas são oportunistas, causam infecções em pacientes internados, com saúde debilitada”, explica Ana Paula. “Este já era um grande problema antes da covid-19 e, agora, estamos evidenciando a piora desse quadro.”
E o uso de antibióticos nos hospitais aumentou muito na pandemia. Estudo publicado na Clinical Microbiology and Infection, em abril deste ano, indicou que mais de 70% dos pacientes internados por covid-19 receberam antibióticos. Mas a presença de coinfecções por bactérias foi estimada em apenas 8%. Em agosto, a Anvisa publicou uma nota técnica com orientações para prevenção e controle da disseminação de bactérias resistentes em hospitais durante a pandemia. A nota reforça que antibióticos não são indicados no tratamento de rotina da covid-19. Esses medicamentos atuam contra bactérias. Os antibióticos são recomendados somente para os casos em que há suspeita de infecção bacteriana associada à infecção viral.